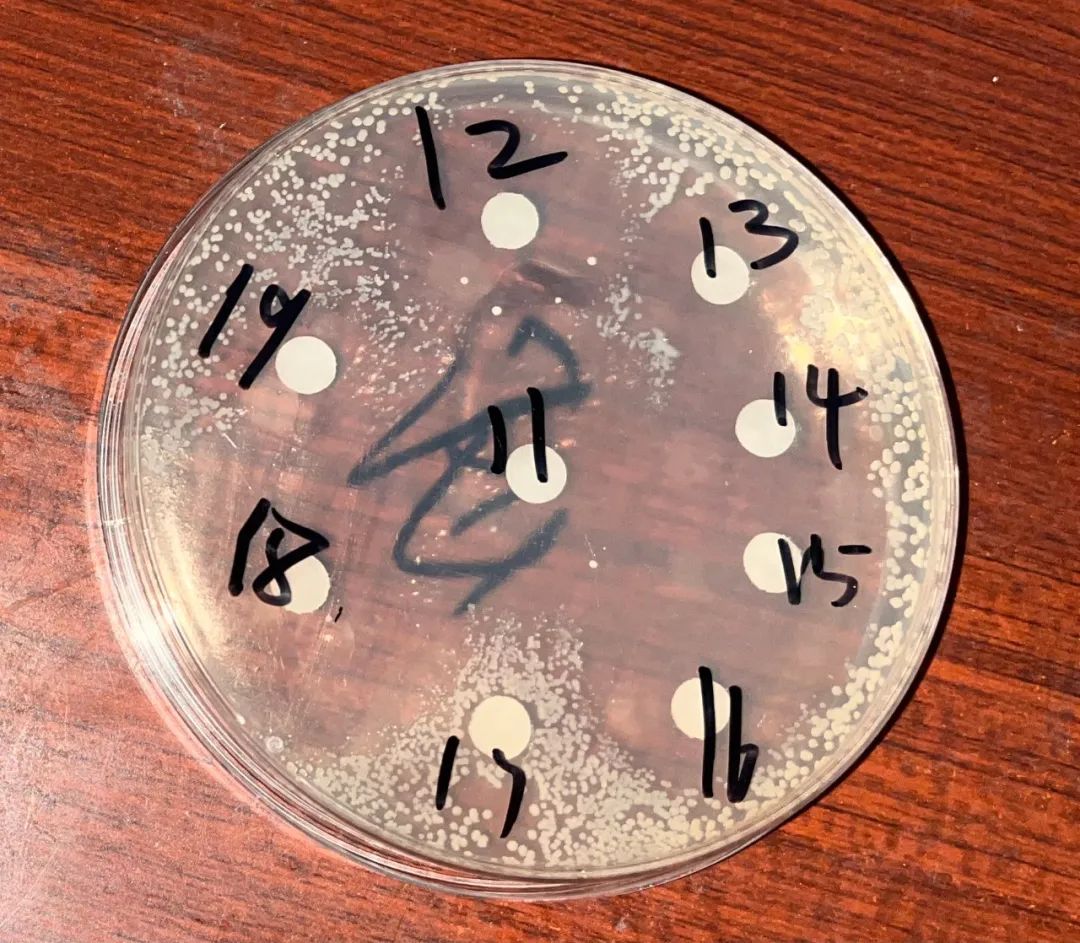
养殖减抗效果突出,养殖用药一览表

在魔高一尺、道高一丈的细菌与抗菌药的较量中,随着用药越来越多,细菌耐药性也越来越强。由此,减抗迫在眉睫,养殖业正面临着一场大考。2018年初,农业农村部启动了兽用抗菌药使用减量化行动试点。短短3年,我国兽用抗菌药使用总量折合纯量由2017年的4.19万吨减少为2020年的3.28万吨,下降了1/5。这1/5的兽用抗菌药是如何减下来的呢?
一位患者因外伤被送到医院救治,医生成功完成手术使其脱离了危险,但患者却意外感染了耐药菌,因为长期使用青霉素、头孢等抗生素的缘故,使用多种抗菌药治疗都不见效,最终,还是不幸离世……这,是电视剧《外科风云》里的一段剧情。
你以为,这只是剧情吗?
在魔高一尺、道高一丈的细菌与抗菌药的较量中,随着用药越来越多,细菌耐药性也越来越强。事实上,近年来人类因滥用抗菌药导致超级耐药细菌频繁出现,已对人类健康构成了严重威胁。为了防止未来无药可用,国家卫生健康委员会数次发布通告,加强抗菌药物的使用管理,医生给我们看病时开抗菌药也越来越审慎。
不仅人类如此,动物也是一样。猪鸡牛羊得了细菌感染引起的疾病也需要使用抗菌药治疗。但如果用得多了,不仅危害动物健康,也会影响人类健康,进而对整个生物链带来危害。
由此,减抗迫在眉睫,养殖业正面临着一场大考。
2018年初,农业农村部启动了兽用抗菌药使用减量化行动试点(以下简称“减抗行动”)。短短3年,我国兽用抗菌药使用总量折合纯量由2017年的4.19万吨减少为2020年的3.28万吨,下降了1/5。
在如火如荼的减抗浪潮中,政府机构、科研院所、养殖主体等都在做什么?他们是如何为消费者提供更安全更优质的肉蛋奶呢?
耐药性随着减药下降了
养殖减抗听起来很陌生,你也许会很疑惑:这和人类健康到底有什么关系?
“人类通过食用畜禽产品摄取能量,若畜禽养殖环节抗菌药物使用超标将造成残留,同时增加动物源和人源细菌耐药性增强的风险,继而导致人感染耐药菌比例增加。所以,兽用抗菌药物减量化行动虽针对畜禽,但对维护人类健康安全也具有重要意义。”国家卫健委抗菌药物临床应用与耐药评价专家委员会委员、武汉大学医院管理研究所常务副所长林丽开教授表示。
具体说来,在生物圈中,人类、动物和环境三者中的微生物环境是一体循环的,人畜排泄物及医疗、农业、工业等领域抗菌药物排放可导致水、土壤等环境中抗菌药物残留,可能加快环境中耐药菌的产生和传播,通过生态循环也可能增加人感染耐药菌的概率,任一环节细菌耐药性升高都会对其他环节细菌耐药性造成影响。
面对动物源细菌耐药性升高可能造成的生物安全考验,自2018年初,农业农村部以推进养殖业绿色发展为目标,突出标准引领、监督指导、技术支撑,集合“政、产、学、研”之力,组织全国各级畜牧兽医主管部门、科研院所、行业主体等开展兽用抗菌药综合治理,在全国引导和推广减抗行动。实施兽药生产质量管理规范、兽药经营质量管理规范;指导养殖场(户)科学合理用药,严格落实休药期制度、处方药制度;实施除中药外的所有促生长类药物饲料添加剂全面退出;实施动物源细菌耐药性监测计划,建立完善动物源细菌耐药性监测数据库……
你应该不知道,在传统养殖中,约有60%的抗菌药添加于饲料中,长期低剂量喂给畜禽,预防畜禽生病,只有40%是用于养殖过程中畜禽生病直接用药。
2019年7月,农业农村部发布第194号公告,决定停止生产、进口、经营、使用除中药外的抗菌药物饲料添加剂。到2020年底,养殖环节已全面停止使用抗菌药物饲料添加剂,实现了饲料禁抗。
国内众多科研院所在减抗替抗领域投入大量精力,致力于研发高效安全的替抗产品,培育抗病力高的新型畜禽品种,研究新型抗菌药检测技术,同时开发新型环境改良剂、消毒剂,提高生物安全水平,减少疫病发生,为减抗工作提供全方位技术支撑。
中国工程院院士、中国农业大学动物医学院院长沈建忠表示:“通过技术创新,积极开发天然植物提取物、有益微生物等替抗产品,研发出一批疗效很高、毒性很低、不容易产生耐药性的动物专用抗菌药物或新制剂,对遏制细菌耐药性的蔓延,保护人类健康有重要意义。”
中国兽医药品监察所、中国兽药协会、中国畜牧业协会等单位依靠专家和专业优势,选聘知名专家授课,对参加减抗试点的养殖场进行减抗政策、安全用药、饲养管理等专业知识培训。同时,制定《养殖场兽用抗菌药使用减量化效果评价方法和标准(试行)》,对试点养殖场进行审核评价,评选出减抗达标养殖场。

“兽用抗菌药使用减量化达标养殖场”标识。
中国兽医药品监察所所长李明介绍,近几年,中监所在全国多个省份开展“科学使用兽用抗菌药”科技下乡活动和科普宣传培训,对广大养殖场(户)和基层群众进行面对面的兽药知识科学宣讲。还收集编写了43家减抗达标场的典型经验案例,推广减抗经验做法,引导更多养殖场开展减抗。
随着减抗宣传力度不断加大,全国各省市积极推动养殖企业参与减抗行动。其中,仅浙江省便有974家养殖场参与减抗试点建设,有726家经评估达到省级标准,有12家通过农业农村部试点评估。3年来,全国316家养殖场报名参加农业农村部减抗试点,有223家通过评估,成为部级试点达标养殖场。
黏菌素,这种被世界卫生组织列为人类极为重要的抗菌药,其耐药率由2015年的38.7%下降至2020年的3.9%,以此为代表,近年来我国养殖环节部分人兽共用抗菌药的耐药率呈下降趋势。数据显示,2017年,我国每吨动物产品兽用抗菌药使用量约为191克,2020年约为165克,下降了13.6%。
2018年,我国兽用抗菌药使用量提前实现“零增长”,2019年、2020年我国兽用抗菌药使用量一降再降,兽药残留和动物源细菌耐药性问题得到有效控制。
这些减抗成效是如何实现的呢?
守好第一道防线
“减抗行动不是某一环节孤零零的工作,它需要养殖所有环节的共同努力。”中国兽医药品监察所标准处处长巩忠福说。
在河北省保定市易县桥头乡西留召的肉鸡养殖基地,一批雏鸡正在进场。
“雏鸡免疫力低,必须做好生物安全防控。”说到鸡苗,河北恩康牧业总经理李小永滔滔不绝。
2014年,李小永刚开始养鸡时,购入的鸡苗质量参差不齐,导致鸡群整体免疫力低下,养殖过程中发病率较高。后来他们发现优质鸡苗抵抗力明显高很多,养殖过程中发病率也低,于是和山东益生、鼎立苗场等种苗场建立了深度合作,购买优质健康鸡苗,极大降低了养殖过程中鸡的发病率,用药量也大幅降低。结合其他一系列措施,公司实现了减抗目标,并在2020年被农业农村部评为全国兽用抗菌药使用减量化行动试点达标养殖场。
恩康牧业药敏试验结果。
良种的防病抗病优势不仅体现在鸡鸭等体型较小的禽类上,在猪牛羊等大型畜种上也体现得淋漓尽致。
“良种奶牛和普通种奶牛可能看起来没区别。但当疾病侵袭时,良种奶牛免疫力高未患病,能正常生产;普通种奶牛免疫力一般,容易患病,用药及休药期间产的奶不得不做无害化处理。如此对比,良种为企业带来的价值优势便瞬间凸显。”河北乐源牧业有限公司优致牧场负责人陈浩介绍,牧场十分注重奶牛品种改良,选择免疫力和抵抗力较强的品种进行选种选育工作,同时,牧场近几年全部施行“自繁自养”,杜绝引种带来的防疫风险,从种源层面加强奶牛免疫力,从而减少抗菌药的使用。
“良种不但能有效提高生产力,还能有效促进企业减少使用抗菌药。河北省从全省范围内选择有一定基础的养殖企业参加减抗试点。通过总结推广试点企业的减抗经验,让更多养殖场加入减抗行动,争取早日实现养殖减抗、健康养殖。”河北省农业农村厅二级巡视员冯雪领介绍。
良种是动物防病的自身优势,要想做好疫病防控,外在环境更加不可忽视。
浙江华腾集团在2013年就开始探索减抗养殖模式。但刚减少使用抗菌药时,华腾旗下嘉华牧场的生猪死亡率由正常的15%提升至35%,造成了巨大的经济损失。
“要想降低生病率、死亡率,便要通过升级生物安全体系减少病菌与猪的接触,改善养殖环境,加强养殖管理,增强猪的抵抗力。”集团养殖中心总经理邵强介绍,他们从牧场建设开始便进行科学规划设计,生产区、生活区、辅助功能区、粪污处理区及洗消区等都经过严密考量,保证各区之间互相隔离,减小养殖区感染风险,构建严密的生物安全防控体系。
同时,制定科学的消毒程序,对场区周边环境、猪舍、人员、车辆、物资等配置不同的消毒方式,保证场内生产安全。就连最容易忽视的水和空气,也经过重重过滤净化,杜绝一切病菌侵入机会。
在养殖过程中,加强饲养管理,通过“全进全出、小群饲养”,减少疾病传播,降低猪群的发病率。并科学制定免疫程序,有计划、有针对性地对猪群疾病进行疫苗预防,尽量保证猪群健康。

华腾集团的现代化猪舍。农民日报·中国农网记者 杨惠 摄
“现在我们的猪舍可高大上了,冬天有地暖加温,夏天有空调、水帘降温,镂空地板让粪便即排即漏,加上自动消毒和除臭系统,小猪们在里面生活得太幸福了。”一谈起减抗养殖技术来,邵强头头是道。
浙江省畜牧农机发展中心饲料兽药处处长徐柏松说道:“别小看这些养殖管理措施,通过上述一系列措施,能有效降低畜禽生病概率,养殖环节防住了病,自然就少用药,减抗目标便能达成。”
对症下药可以四两拨千斤
第一道预防关守住了,畜禽没得病,这自然是极好的。倘若没守住呢?莫慌,还有第二招——精准用药。
“自2020年10月起,本养殖场已连续多批发生类似疾病,发病猪体温高、精神差、呼吸急,多种抗菌药物注射治疗效果不佳,病死率50%以上。自场PCR(一种分子生物学技术)检测非洲猪瘟、猪瘟、蓝耳、圆环、支原体全部阴性,发病原因需进一步查找。”在浙江省衢州市衢江区大美山生猪养殖场的兽医诊疗记录上,有着这样的记录。
诊疗记录显示,2020年10月—2021年6月,该养殖场的生猪一直受不明原因疾病困扰,猪场损失巨大。
养殖场老板董洪明具有丰富的乡村兽医工作经验,却也找不出发病原因。董洪明挠了挠头,窘迫地说:“这都怪我们技术不精,在做PCR检测时没有正确取样,造成结果严重偏差,加上非洲猪瘟防控原因,专业技术人员进不了猪场进行检查,才耽误了这么久。”
原来,在检测支原体时,董洪明只采集了血清样本,结果显示支原体感染阴性。殊不知,支原体检测需要采集咽拭子或发病猪肺部组织才能得到准确结果。
直到2021年7月,他们正确采集了检测样本,结果显示支原体阳性,才找到发病的真正原因。说到这里,董洪明长舒了一口气。
找准发病原因,再配合药敏试验检测出的有效防治药物,兽医迅速对症精准用药,猪群的病情很快便控制住了。
在推进减抗行动过程中,浙江省衢州市把工作重点放在了提升诊疗水平、促进精准用药上。药敏试验便是其中一个主要内容,让有条件的养殖场通过药敏试验检测出针对场内致病菌群的有效药物,推动诊疗过程精准用药,从而实现抗菌药减量化。
“药敏试验的意义在于保障精准用药,而精准用药的目的是实现抗菌药减量。”衢州市畜牧业发展中心副主任翁锡良介绍说,在培养皿的培养基上均匀涂布养殖场内采集的菌种,贴上不同的药敏片,恒温箱培养一天后菌落根据耐药性不同而长势不同。药敏片周围抑菌直径越大,说明菌种对该药物越敏感,反之则不敏感。找出了有效药物便能在用药过程中实现精准用药。
翁锡良介绍,在检测经费保障上,2021年衢州市专门从三农专项资金中落实经费50余万元,全市统一解决采样检测经费。拨出18万元经费用于细菌耐药性监测工作,在6个县区的29个试点场布置开展细菌耐药性监测,并统一招标、择优选定第三方检测机构,保障检测标准全市统一,确保检测数据准确有效。“今年将继续安排20万元用于32个养殖场的细菌耐药性监测,以指导科学用药。”翁锡良说。
非洲猪瘟传入我国后,衢州市要求生猪存栏5000头以上的养殖场必须建设PCR检测实验室,并鼓励有条件的养殖场开展药敏试验。不少像董洪明一样有远见的小养殖户在政府部门的引导支持下也建起了实验室,有效促进了疫病防控和诊疗水平的提升。
衢州温氏畜牧有限公司采用“公司+农户”的养殖模式,与当地600多户农户合作,年出栏肉鸡2000万只。如此多农户,怎么做到养殖减抗、精准用药?公司除了加强对养殖户日常养殖管理的技术指导外,还运用药敏试验等技术手段为养殖户生病鸡群进行检测,指导养殖户精准用药。
“2021年,公司光药物支出费用便比上年减少了400万元。”公司总经理刘迪介绍,精准用药大幅减少了抗菌药的使用量,养殖效益肉眼可见。
给抗菌药找“替身”
少用或不用抗菌药,可以用哪些更健康的“替身”呢?天然植物提取物、有益微生物、寡糖多糖类、免疫活性肽、酶制剂、酸化剂等新产品纷纷登场,其研发应用掀起了热潮。
浙江省金华市金婺农业发展有限公司总经理冯伟峰夫妻俩都是南京农业大学动物医学专业硕士研究生,毕业后便在饲料企业做技术服务。当时,国内还没有实行饲料禁抗,夫妻俩看到众多养殖场都使用添加抗菌药的饲料,对食品安全日渐担忧。有了女儿后,他们想让女儿吃到健康食物的想法越来越强烈。
夫妻俩一合计,决定先找一家蛋鸭养殖户做实验,试试减抗养殖,利用自身丰富的专业知识,研究使用益生菌发酵饲料。
“在人和动物的肠道中有大量菌群,当有害菌达到一定数量,肠道功能就会紊乱从而生病。鸭子吃料后益生菌进入鸭肠道并定植,减少有害菌生存空间,鸭子就能少生病,长势也更好。”冯伟峰介绍了实验原理。
一间200平方米的小鸭舍、近2000只老弱病残鸭,这是当时夫妻俩的实验对象。“通风不好,鸭子密度也大,刚一进去氨气的味道简直能把人熏晕过去。”冯伟峰对当时的场景印象深刻。经过实验,鸭舍内氨气减少了,鸭子们不仅健康多了,产蛋率和蛋品质量也明显提高了,他们的实验成功了!
然而实验虽然成功了,但成本更高的益生菌发酵饲料饲养的鸭子产出的鸭蛋价格并不比普通鸭蛋价格高,没有农户愿意和他们合作。
怎么办呢?夫妻俩决定自己创业。在他们的养殖场,除雏鸭阶段必要治疗时使用抗菌药外,产蛋期完全不使用抗菌药,全程使用益生菌发酵饲料。生产出的绿色鸭蛋产品受到消费者喜爱,每斤价格比普通鸭蛋高出4元左右,供不应求。
除了益生菌,中草药替抗也成了热门。
“饲料禁抗后,植物提取物在饲料领域具有更加广阔的应用前景。”国家植物功能成分利用工程技术研究中心副主任、湖南农业大学教授曾建国表示。
从1991年起,曾建国团队历时20多年研发,将博落回提取物成功开发为我国首个二类中兽药及药物饲料添加剂。因其“抗炎、整肠、促生长”作用,作为替抗产品在国内外70多个国家和地区使用。
北京德青源农业科技股份有限公司经过多次试验,发现使用黄芪等可以提高鸡群抵抗力,在免疫、转群之前使用维生素等产品可以减少鸡群应激,使用麻杏石甘口服液等中药制剂能治疗鸡群呼吸道疾病,完全可以用来替代抗菌药。多措并举,大幅减少了抗菌药的使用量。
除了养殖企业自身试验研究,政府部门、行业协会等也大力提倡替抗产品研发。山东、河北等省依托丰富的中药材资源,大力发展兽用中药产业,积极推动中草药添加剂等替抗产品应用,为养殖场减抗、替抗提供了更多选择。
减抗终将成为风尚
减抗当然好,也可行,不过要付出的代价和面临的风险也不小。
对于养殖企业而言,一方面要承受减少使用抗菌药初期畜禽产量减少或死淘率升高的风险;另一方面,强化养殖管理就要在引种、圈舍设施、疫病检测等方面投入更多成本。养殖综合成本提升是企业减抗面临的难题。
“盈利是企业生存的根本,而防病则是减抗的根基。”翁锡良表示,从近三年推广减抗行动工作的经验来看,在一些技术实力雄厚的大型养殖企业推广减抗更易成功,而中小型养殖企业的推广工作仍然有一定困难,主要原因就在于部分中小养殖场技术力量不足,抱有“嫌麻烦”“怕增成本”的心态。
为激励企业参与减抗行动,贵州省先后投入266万元支持260个规模养殖场开展减抗试点工作,此外,河北、浙江、四川等多省均投入专项资金用于开展减抗试点建设工作,对于达标养殖场进行不同程度的资金奖励。
除了政府资金支持,如果消费市场能够予以认可,给予价格回报,就能抵消企业增加的成本,提升企业参与减抗行动的积极性。
“但现实情况更多是企业通过养殖减抗生产出了更优质、更安全的畜禽产品,而消费者却对其知之甚少。”河北省农业农村厅畜禽屠宰与兽药饲料管理处副处长吴涛表示,实现畜禽产品优质优价,让企业得到切实效益,才能长期、可持续地推进减抗行动。
为此,农业农村部畜牧兽医局除了加强减抗理念的宣传,还会同国家卫生健康委医政医管局举办“年度提高抗微生物药物认识周”活动,组织开展“科学使用兽用抗菌药百千万接力公益行动”等,提高公众对养殖减抗重要性的认识。

消费者在华腾门店购买猪肉。
随着减抗理念逐渐深入人心,很多参与减抗行动的养殖企业也获得了经济收益回报和品牌信誉提升。
在华腾集团的门店,通过减抗方式生产出的“桐香”牌猪肉产品深受消费者喜爱,特别是“桐香”猪肝,即使售价高达每斤48.8元,仍被消费者订购一空。
“精细化的科学养殖促进鸡的健康成长,严格合规使用兽用抗菌药,让餐饮采购商能够安心使用我们的产品,这是我们对企业信誉的严格要求。”嘉吉蛋白的有关负责人说。
作为全球最大的肉类和禽类加工商之一,嘉吉蛋白在我国主要进行肉鸡养殖和肉类产品加工。2020年,嘉吉肉鸡养殖农场被农业农村部评为全国首批81家兽用抗菌药使用减量化行动试点达标养殖场之一,他们生产加工的肉类产品也供应给麦当劳等多家知名连锁餐饮企业,销售效益可观。
今年3月,“兽用抗菌药使用减量化达标养殖场”标识制定并发布,经省级以上畜牧兽医主管部门评估达标的养殖场(户),可自愿选择使用该标识。目前,各省正紧锣密鼓地制定该标识使用的具体方案,不久以后,消费者们便可以看标选购了。
也有消费者对减抗认识有误区,认为既然使用抗菌药有风险,为什么不直接“零使用”?
对此,沈建忠表示,治疗动物的细菌性感染目前最直接有效的方法依然是使用抗菌药。如果畜禽细菌感染却不使用抗菌药进行治疗,反而会影响食品安全。只要科学使用兽用抗菌药,检测残留量符合国家标准,对人体的健康就是无害的。减抗行动是要解决抗菌药滥用、乱用问题,所以,我们提倡养殖减抗而不是养殖无抗。
前景向好,从业者正在攻克一个又一个难题,推动行业向更大范围、更深层次进行养殖减抗。
目前,我国兽用抗菌药使用减量化工作步入下一阶段,农业农村部发布的《全国兽用抗菌药使用减量化行动方案(2021—2025年)》为未来5年的减抗行动指明了方向。到2025年末,全国半数规模养殖场将实施养殖减抗行动,为畜禽健康和人类健康做出更多探索实践。
养殖减抗,关乎食品安全和人类健康的革命,是养殖业绿色健康发展的必由之路,起步虽艰,终将行远。
(图片除署名外均由受访者提供)
作者:农民日报·中国农网记者 杨惠 刘一明

【版权声明】本文著作权归农民日报所有,未经授权,不得转载。